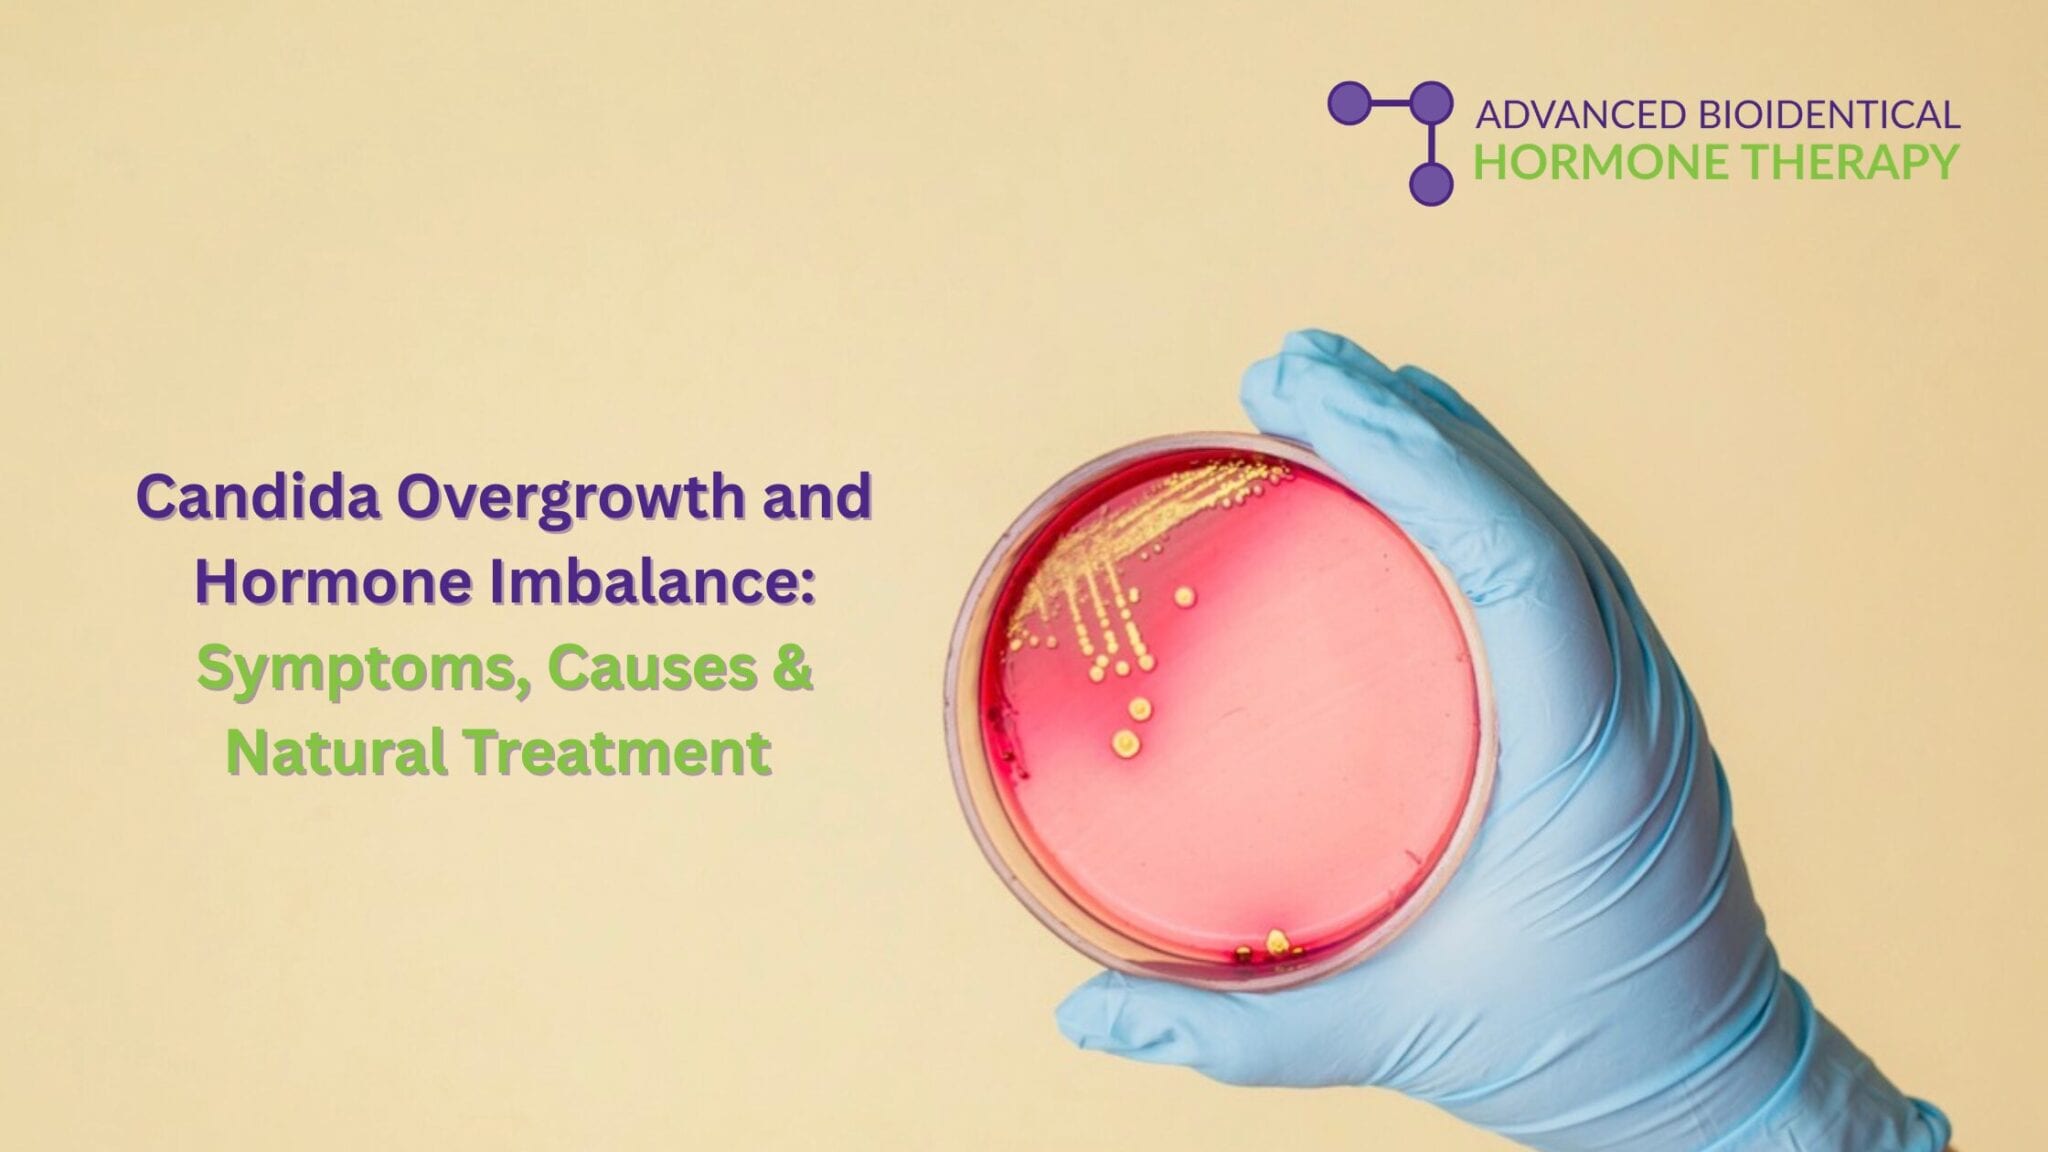
Candida Overgrowth and Hormone Imbalance: Symptoms, Causes & Natural Treatment

Are You Plagued with Candida overgrowth?
Candida overgrowth and hormonal imbalances are deeply interconnected, creating a vicious cycle in which high estrogen levels fuel yeast growth, and the resulting Candida toxins further disrupt hormones. Estrogen promotes Candida, which can lead to chronic, recurrent yeast infections.
Key Connections Between Candida Overgrowth and Hormone Imbalances:
- Estrogen Fueling Infection: High estrogen levels (during pregnancy, menopause, or from birth control pills) can weaken the immune system’s ability to fight Candida albicans, leading to increased vaginal yeast infections
- Hormone Mimicry: Candida by-products can mimic estrogen in the body, resulting in estrogen dominance.
- Thyroid and Stress Hormones: Candida overgrowth is often associated with elevated cortisol (stress hormone) and may exacerbate thyroid issues, such as Hashimoto’s disease.
- Symptoms of Imbalance: Along with infections, Candida overgrowth may present with symptoms linked to hormonal shifts, including severe fatigue, brain fog, sugar cravings, and irritability.
Managing Candida often requires addressing the root cause of the hormonal imbalance through diet which includes a low-sugar and low-carb “Candida diet,” stress reduction, and potential antifungal support to rebalance the microbiome.
At AB Hormone Therapy we do a natural Candida cleanse approach combined with Nystatin, an antifungal prescription to eliminate yeast in the gut, while adopting a sugar-free, low-carb diet (leafy greens, garlic, coconut oil) to prevent regrowth. Probiotics should be taken separately from Nystatin to restore healthy bacteria.
What Is The Candida Overgrowth Treatment Combined Approach?
- Nystatin Treatment: Nystatin is safe for managing digestive tract Candida because it is not absorbed into the bloodstream, meaning it does not affect the liver or kidneys. It is often used to treat oral thrush (swished 4 times daily) and intestinal overgrowth.
- Dietary Changes: A “no-sugar” diet is essential to starve the yeast. Recommended foods include:
- Low-glycemic fruits & veggies: Leafy greens, carrots, cucumbers, berries, and avocados.
- Antifungal foods: Garlic, coconut oil (caprylic acid), oregano, ginger, and cinnamon.
- Probiotics: Essential for restoring good gut bacteria, but should be taken at a different time than Nystatin to prevent the medication from killing the probiotic bacteria.
- Natural Remedies:
- Caprylic acid: Found in coconut oil, this helps destroy yeast.
- Botanical mouthwashes: Herbal blends like Zataria multiflora and Satureja bachtiarica have shown antifungal properties.
Things to Consider:
- “Die-Off” Symptoms: As Candida dies, it may release toxins, causing temporary symptoms.
- Consult a professional: It is highly recommended to consult an AB Hormone Specialist to confirm a Candida diagnosis and determine the appropriate dosage for Nystatin.
Frequently Asked Questions About Candida Overgrowth
What are the symptoms of Candida overgrowth?
Common symptoms include chronic yeast infections, fatigue, brain fog, sugar cravings, bloating, mood swings, and hormone imbalance symptoms such as estrogen dominance.
Can hormone imbalance cause Candida overgrowth?
Yes. High estrogen levels can weaken immune defenses and promote yeast growth. Estrogen dominance and Candida often create a cycle that worsens both conditions.
How long does it take to treat Candida overgrowth?
Treatment time varies depending on severity. With antifungal therapy like Nystatin and dietary changes, many patients begin noticing improvement within a few weeks.
Is Nystatin safe for Candida treatment?
Nystatin is considered safe for digestive Candida because it is not absorbed into the bloodstream and does not stress the liver or kidneys when used appropriately under medical supervision.
Should probiotics be taken during Candida treatment?
Yes, probiotics help restore healthy gut bacteria. However, they should be taken at a different time than antifungal medications to ensure effectiveness.